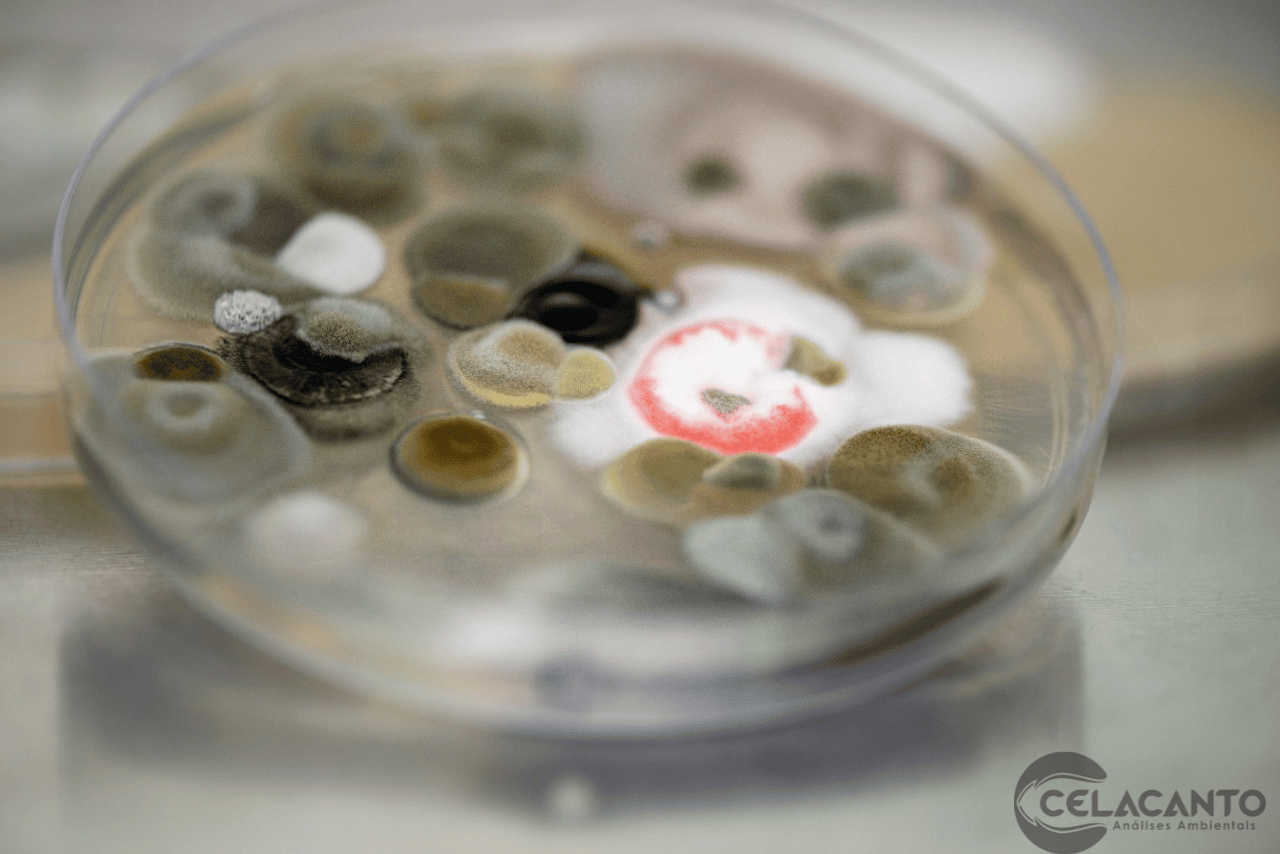
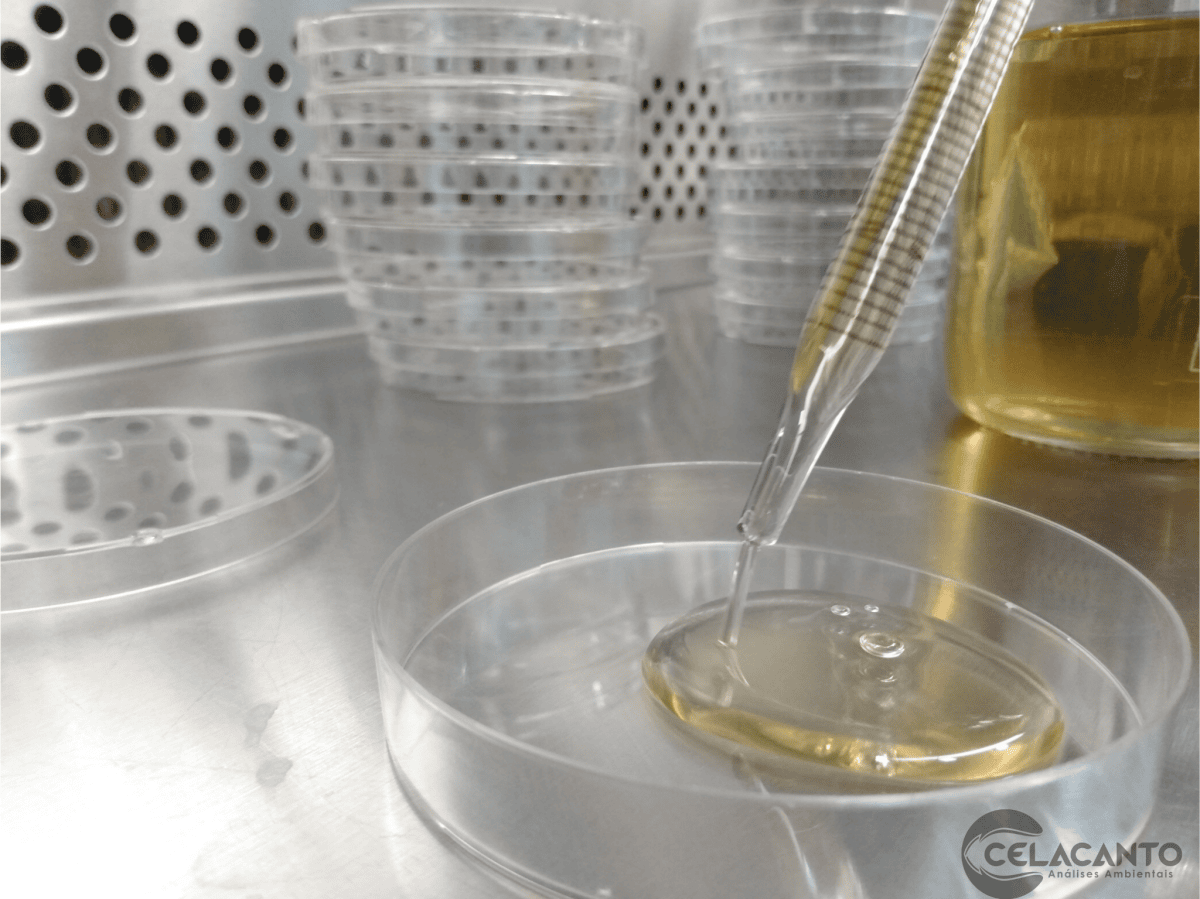
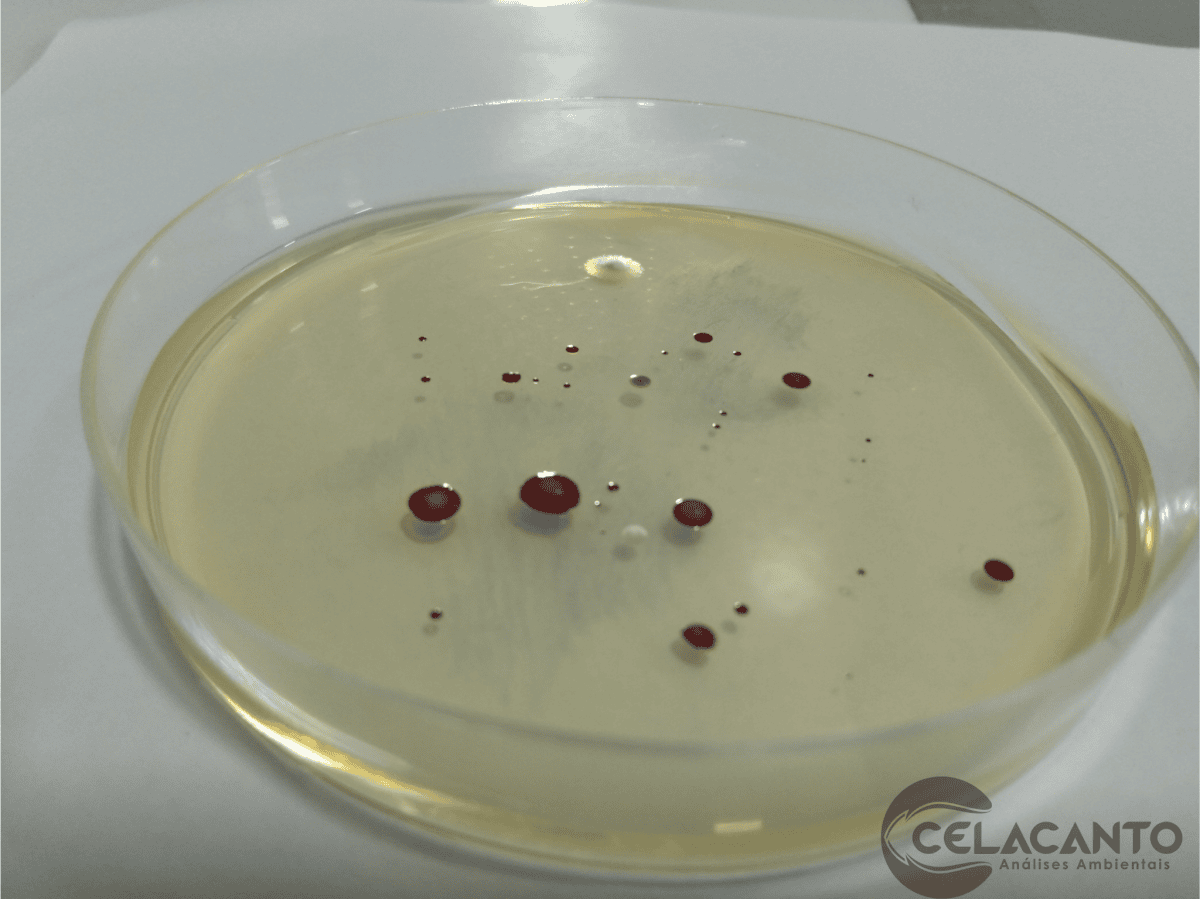
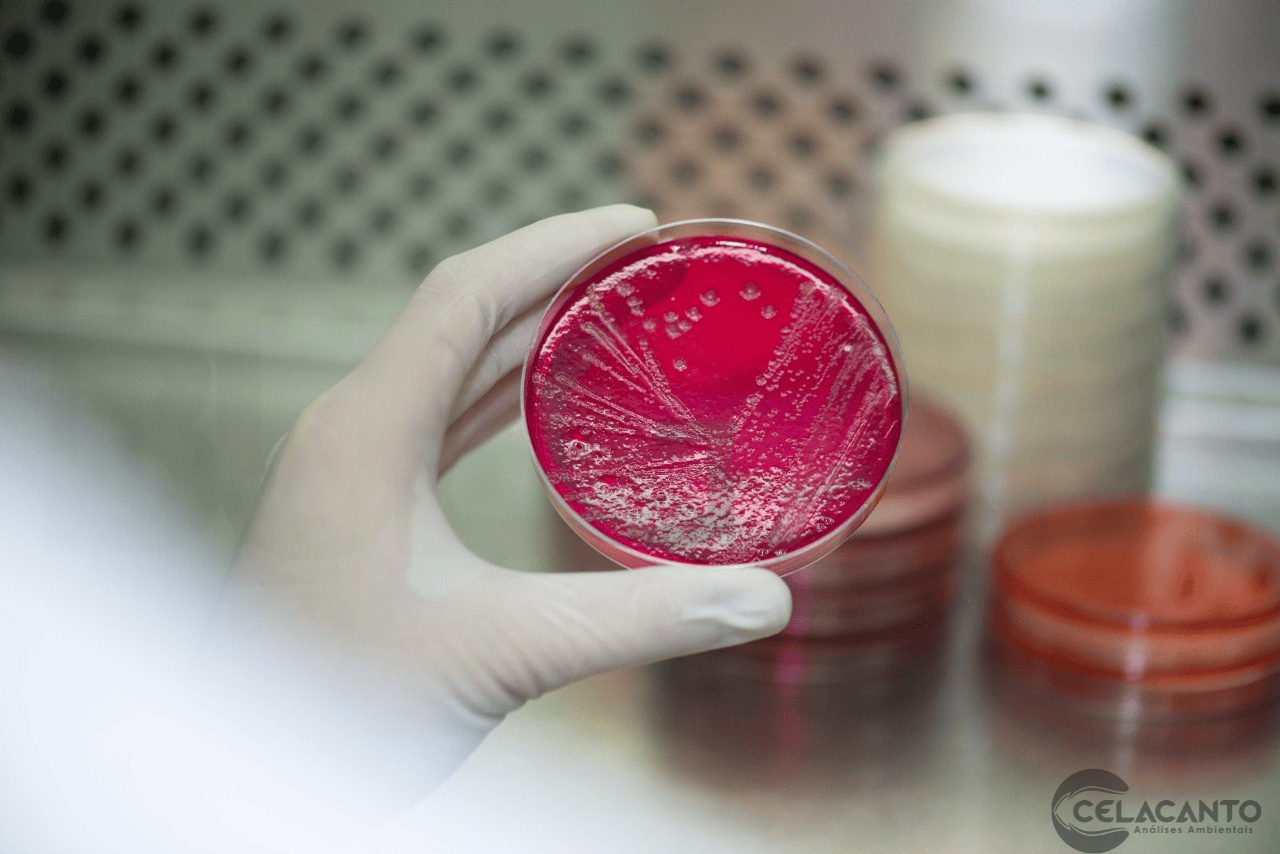

Galeria de Fotos
Menu
Menu Principal Celacanto Análises e Qualificações LTDA | Análises Laboratoriais de Qualidade
HomeServiços Análise da Qualidade do Ar ComprimidoAnálise da Qualidade do Ar em Ambientes Climatizados NBR 17037Análise Microbiológica de ÁguaAnálise Microbriológico e Físico-Química de Alimentos e BebidasCompostos Orgânicos Voláteis e Semi-Voláteis (VOC e SVOC)Estudo de Estabilidade para Suplementos AlimentaresEstudo de Shelf Life para Alimentos, Bebidas e IngredientesHigiene OcupacionalQualificação de Capelas de ExaustãoQualificação de Fluxo LaminarQualificação de Salas Limpas e Sistemas de HVACQualificação Térmica de Almoxarifado e Câmara FriaSanitização de AmbienteServiços de EngenhariaValidação de LimpezaValidação de Método AnalíticoValidação de ProcessosValidação de Sistemas Computadorizados (VSC)
Contato
Fale conosco